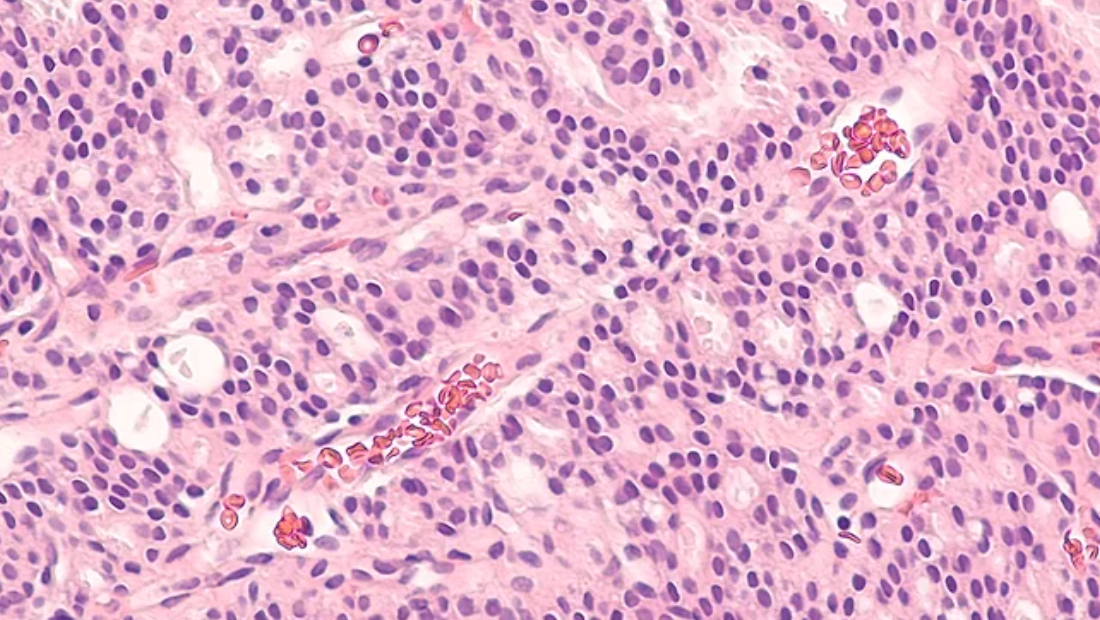
Advancing Hope for Prostate Cancer Patients: Johnson & Johnson Acquires Halda for $3.05B

Our team is excited about the $3.05B acquisition of our portfolio company, Halda Therapeutics, by Johnson & Johnson
In 2019, following the success of another Canaan portfolio company, Arvinas, which they had started in 2013, Craig Crews of Yale and Tim Shannon of Canaan helped start a new biotech company called Halda. The company quickly attracted great talent and investors and went on to create another entirely novel class of medicine, called RIPTACs™
RIPTACs™ have the potential to offer stronger, more targeted cancer treatments by activating a killing signal only within tumor cells, thereby reducing side effects and improving patients’ quality of life compared to traditional therapies. In 2024, Canaan Executive in Residence, Chris Schade, took charge as President and CEO as the company transitioned to a clinical-stage company.
Halda reflects an approach we take when building biopharma companies at Canaan: identifying promising early science, partnering with a syndicate of knowledgeable investors, shaping the strategy from the outset, assembling the founding team, and helping bring the products to patients in clinical trials.
This November, Halda’s Phase 1 clinical data in patients with advanced metastatic prostate cancer were presented at a major medical conference. Treatment with Halda’s medicine, HLD-0915, resulted in profound benefit for these patients, which was even more striking given that they had failed all other available options. As one employee noted, many patients will enjoy the year-end holidays in much better spirits and with newfound hope thanks to Halda and HLD-0915.
We are thrilled that a world leader in the treatment of patients with prostate cancer, Johnson & Johnson, will use its vast talent and resources to get HLD-0915 through advanced clinical development, approval, and to patients worldwide. There is still much work to be done, but the Halda programs are in great hands.
This is a great result for Canaan, its limited partners, and other Halda investors who had the courage to create something entirely novel to help patients. The potential importance and impact on patients treated with HLD-0915 and other Halda programs are reflected in the value we will share.
We are fortunate to be part of a society that supports us in meeting the challenges we all face as humans. We are grateful to the patients who take the risk to help us understand new medicines. Finally, we are thankful to the talented and committed employees of Halda who worked creatively, skillfully, and tirelessly on the Halda programs.
For more information about the acquisition of Halda by Johnson and Johnson, you can read the news releases issued by Halda and Johnson & Johnson: